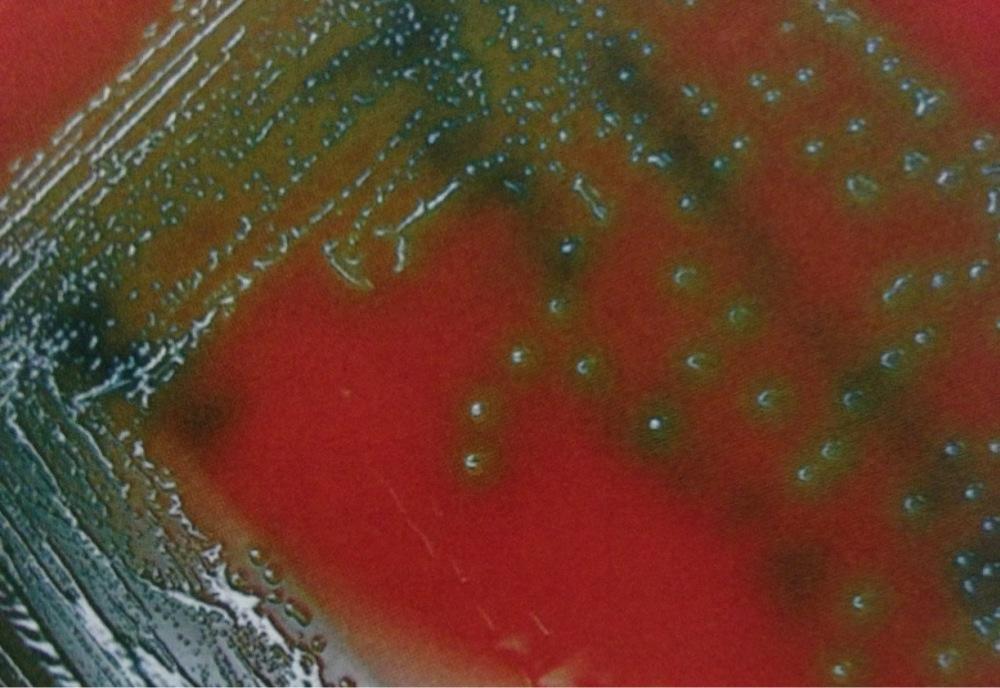

Which Staphylococci are Novobiocin resistant? Which are sensitive?
What Streptoocci are Opticin sensitive and resistant? What about Bacitracin?
” On the office’s “staph” retreat, there was NO StRESs. : NOvobiocin—Saprophyticus is Resistant; Epidermidis is Sensitive.
OVRPS (overpass). Optochin—Viridans is Resistant; Pneumoniae is Sensitive
B-BRAS: Bacitracin—group B strep are Resistant; group A strep are Sensitive.
What organisms are α-hemolytic bacteria
Form green ring around colonies on blood agar A . Include the following organisms: Streptococcus pneumoniae (catalase ⊝ and optochin sensitive)
Viridans streptococci (catalase ⊝ and optochin resistant)
What bugs are B hemolytic
Staphylococcus aureus (catalase and coagulase ⊕)
Streptococcus pyogenes—group A strep (catalase ⊝ and bacitracin sensitive)
Streptococcus agalactiae—group B strep (catalase ⊝ and bacitracin resistant)
Listeria monocytogenes (tumbling motility, meningitis in newborns, unpasteurized milk)
Gram + bacteria. Has a Protein A virulence factor taht binds Fc-IgG and inhibits complementa activation. Lives in Nose
What diseases does it cause?
Staph. Aureus
You and your roomate come back from a lunch hosted by school and both start vomitting profusely. Ingestion of what preformed toxin would cuase that rapid of onset?
S. aureus food poisoning due to ingestion of preformed toxin–>short incubation period (2–6 hr) followed by nonbloody diarrhea and emesis. Enterotoxin is heat stable not destroyed by cooking.
A teamate of yours was playing soccer and got elbowed right in the nose. The trainer packed his nose and has him ice to help with the swelling. The next day at school your buddy wasn’t there and you were told he was taken to the ER last night- he has a fever of 101 and was vomitting and covered in a rash. What bug is responsible and what is the mechanism responsible for the pts symptoms
TSST is a superantigen that binds to MHC II and T-cell receptor, resulting in polyclonal T-cell activation. Staphylococcal toxic shock syndrome (TSS) presents as fever, vomiting, rash, desquamation, shock, end-organ failure. Associated with prolonged use of vaginal tampons or nasal packing. Compare with Streptococcus pyogenes TSS (a toxic shock– like syndrome associated with painful skin infection).
Infects prosthetic devices (e.g., hip implant, heart valve) and intravenous catheters by producing adherent biofilms. Component of normal skin flora; contaminates blood cultures. Novobiocin sensitive.
Staph. Epidermidis: Gram +, Catalase +, Coag - and Novobiocin resistant
Second most common cause of uncomplicated UTI in young women (first is E. coli). Novobiocin resistant.
Staphy. Saphrophiticus
Gram +, Coag +, Cat -, Novo resistant (Cow don’t get UTIs)
Strep. Pneumo is implicated in many common disesase: which are they?
What does this bug look like?
S. pneumoniae MOPS are Most OPtochin Sensitive.
Meningitis, Otitis Media, Pneumonaie, Sinusitis
Lancet-shaped, gram-positive diplococci: Encapsulated. IgA protease.

You are treating a little boy that is in the office becaues his mother says his H.influenza virus “is back”. He was in the week before and tested + for H.flu, was given antiB and sent home. Your PE is significant for diffuse lobar consolidation on both sides as well as rusty sputum which he coughed on your face.
What is the Dx?
What’s the key virulence factor?
Streptococcus pneumoniae
pneumococcus is associated with “rusty” sputum, sepsis in sickle cell disease and splenectomy.
No virulence without capsule.
α-hemolytic. They are normal flora of the oropharynx that cause dental caries (Streptococcus mutans) and subacute bacterial endocarditis at damaged heart valves (S. sanguinis). Resistant to optochin, differentiating them from
S. pneumoniae, which is α-hemolytic but is optochin sensitive
Viridans group streptococci
Pneumonics to remember the Viridians group streptococci
Sanguinis = blood. Think, “there is lots of blood in the heart” (endocarditis).
S. sanguinis makes dextrans, which bind to fibrin-platelet aggregates on damaged heart valves.
Viridans group strep live in the mouth because they are not afraid of-the-chin (op-to-chin resistant).
Group A Strep.Pyogenes causes many diseases, name as many as you can:
Pyogenic—pharyngitis, cellulitis, impetigo, erysipelas
Toxigenic—scarlet fever, toxic shock–like syndrome, necrotizing fasciitis
Immunologic— rheumatic fever, acute glomerulonephritis
Bacitracin sensitive, β-hemolytic, pyrrolidonyl arylamidase (PYR) ⊕.
What bacteria does this describe
Streptococcus pyogenes (group A streptococci)
Antibodies to ________ enhance host defenses against S. pyogenes but can give rise to rheumatic fever.
_______detects recent S. pyogenes infection.
M protein
ASO titer
Little boy comes to the office with a diffuse rash on his face as seen below
What bacteria is responsible for this?
What other skin associations are associated?

Streptococcus pyogenes (group A streptococci)
pharyngitis, cellulitis, impetigo, erysipelas
Little girls comes to the office with her mother who is very concerned as she said her daughter has been recently peeing blood. Her daughter has a bad sore throat a few days before. What bacteria is involved?
titers would be elevated in this patient?
Streptococcus pyogenes (group A streptococci)
ASO titer detects recent S. pyogenes infection.
Pharyngitis can result in rheumatic “phever” and glomerulonephritis.
Impetigo more commonly precedes glomerulonephritis than pharyngitis.
Little boy comes in with a rash all over his body, rough texture. On PE you see a strawberry tongue. What bacteria is responsible? What other body systems may become involved?

Streptococcus pyogenes (group A streptococci)
may see subsequent desquamation and glomerulonephritis
What are the Jones criteria?
Is be bactiera Bacitracin resistant or sensitive?
J♥NES (major criteria for acute rheumatic fever):
Joints—polyarthritis ♥—carditis–Nodules (subcutaneous) Erythema marginatum Sydenham chorea
Streptococcus pyogenes (group A streptococci)
Screen pregnant women at 35–37 weeks of gestation. Patients with ⊕ culture receive intrapartum penicillin prophylaxis
Streptococcus agalactiae (group B streptococci)
–Group B for Babies!
Bacitracin resistant, β-hemolytic, colonizes vagina; causes pneumonia, meningitis, and sepsis, mainly in babies.
Streptococcus agalactiae (group B streptococci)
What is the mechanism of action of infection of Group B strep?
Produces CAMP factor, which enlarges the area of hemolysis formed by S. aureus. (Note: CAMP stands for the authors of the test, not cyclic AMP.) Hippurate test ⊕.
are normal colonic flora that are penicillin G resistant and cause UTI, biliary tract infections, and subacute endocarditis (following GI/GU procedures).
Enterococci (E. faecalis and E. faecium)
________ is based on differences in the C carbohydrate on the bacterial cell wall. Variable hemolysis.
VRE (vancomycin-resistant enterococci) are an important cause of _______
Lancefield grouping
nosocomial infection.





